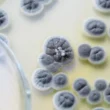

الكبد عضو حيوي يؤدي عددًا لا يحصى من الوظائف الهامة، بدءًا من إزالة السموم من الجسم وصولاً إلى المساعدة في عملية الهضم. ومع ذلك، فهو عرضة أيضًا لمشاكل صحية مختلفة، بما في ذلك مرض الكبد الدهني. غالبًا ما تمر هذه الحالة، التي تتميز بتراكم الدهون الزائدة في الكبد، دون أن يلاحظها أحد في مراحلها المبكرة.
لذلك، يصبح فهم كيفية تحليل دهون الكبد أمرًا بالغ الأهمية للتشخيص المبكر والإدارة الفعالة. يرشدك هذا المقال إلى طرق التشخيص الأساسية ويوضح سبب أهمية الكشف المبكر لرفاهك العام.
- ما هو الكبد الدهني ولماذا يهمنا؟
- أهمية الكشف المبكر عن دهون الكبد
- كيفية تحليل دهون الكبد: الفحوصات التشخيصية
- أنواع الكبد الدهني وأسباب الإصابة
- الخلاصة: صحة كبدك بيدك
ما هو الكبد الدهني ولماذا يهمنا؟
الكبد عضو حيوي ينفذ مهام لا تحصى، مثل تصنيع البروتينات، عوامل تخثر الدم، وحتى الدهون الثلاثية والكوليسترول اللازمة للجسم. ينتج الكبد ويفرز المادة الصفراء الضرورية للهضم، ويخزن الطاقة.
مرض الكبد الدهني يحدث عندما تتراكم كميات كبيرة من الدهون في خلايا الكبد، مما يعيق أداءه السليم لوظائفه. هذه الحالة قد تتطور إلى مشاكل صحية أكثر خطورة إذا لم تُعالج.
أهمية الكشف المبكر عن دهون الكبد
غالبًا ما يتقدم مرض الكبد الدهني بصمت دون أعراض واضحة في مراحله المبكرة. يمكن أن يؤدي تراكم الدهون المستمر إلى التهاب وتلف الكبد، وقد يتطور إلى تليف الكبد أو حتى الفشل الكبدي.
التشخيص المبكر يمنحك الفرصة لاتخاذ خطوات علاجية ووقائية فعالة. يتيح لك فهم وضع كبدك الحقيقي وتحديد المسار الأنسب للحفاظ على صحته ومنع تفاقم المرض.
كيفية تحليل دهون الكبد: الفحوصات التشخيصية
لتشخيص مرض الكبد الدهني بدقة، يعتمد الأطباء على مجموعة من التحاليل والاختبارات المتكاملة. هذه الفحوصات ضرورية لتحديد مدى تراكم الدهون وتقييم صحة الكبد بشكل عام.
فحوصات الدم: مؤشرات حيوية
تُعد تحاليل الدم الخطوة الأولى في الكشف عن دهون الكبد. يطلب الأطباء عادةً اختبارات الدم التي تكشف عن ارتفاع في إنزيمات الكبد مثل ناقلة أمين الألانين (ALT) وناقلة أمين الأسبارتات (AST).
يشير ارتفاع هذه الإنزيمات إلى وجود التهاب أو تلف في الكبد. قد تُجرى هذه الاختبارات كجزء من الفحوصات الروتينية، أو عند ظهور أعراض معينة على المريض. إذا كانت نتائج الإنزيمات مرتفعة، سيطلب الطبيب المزيد من الفحوصات لتحديد السبب الدقيق للالتهاب.
خزعة الكبد: نظرة عميقة
تعتبر خزعة الكبد أدق وسيلة لتشخيص الكبد الدهني وتحديد شدة المرض. يتضمن الإجراء إدخال إبرة رفيعة إلى الكبد لسحب عينة صغيرة من الأنسجة.
يفحص أخصائي علم الأمراض هذه العينة تحت المجهر لتحديد وجود الدهون، ودرجة الالتهاب، وأي تندب في الكبد (Liver scarring). عادةً ما تُجرى الخزعة تحت التخدير الموضعي لضمان راحة المريض.
الفحوصات التصويرية: رؤية واضحة
تساعد الفحوصات التصويرية الأطباء على رؤية الكبد وتقييم مدى تراكم الدهون دون الحاجة إلى إجراء جراحي. تُستخدم هذه الاختبارات لتأكيد التشخيص واستبعاد حالات أخرى.
تشمل هذه الفحوصات: الموجات فوق الصوتية (Ultrasound)، والتصوير الطبقي المحوري (CT Scan)، والتصوير بالرنين المغناطيسي (MRI). تقدم كل طريقة منها رؤية مختلفة ومعلومات قيمة حول حالة الكبد.
أنواع الكبد الدهني وأسباب الإصابة
يُعرف الكبد الدهني بتراكم الدهون في خلايا الكبد، وينقسم أساسًا إلى نوعين رئيسيين:
- مرض الكبد الدهني اللاكحولي (NAFLD): هذا النوع يحدث لدى الأشخاص الذين لا يتناولون الكحول بكثرة. غالبًا ما يرتبط بعوامل مثل السمنة، مقاومة الإنسولين، داء السكري من النوع الثاني، وارتفاع الكوليسترول والدهون الثلاثية. قد يتطور إلى التهاب الكبد الدهني اللاكحولي (NASH) الذي يمكن أن يؤدي إلى تليف الكبد.
- التهاب الكبد الدهني الكحولي (ASH): ينجم هذا النوع عن الإفراط في تناول المشروبات الكحولية. مع مرور الوقت، يؤدي الكحول إلى تراكم كميات كبيرة من الدهون في خلايا الكبد، مما يعيق قدرته على العمل بشكل طبيعي ويسبب التهابًا وتلفًا.
حتى في غياب تناول الكحول، يمكن أن تتراكم الدهون في الكبد وتسبب ما يسمى “الكبد الدهني البسيط”، حيث لا يوجد التهاب أو تليف مبدئي. ومع ذلك، من المهم دائمًا مراقبة الحالة واتخاذ الإجراءات اللازمة.
الخلاصة: صحة كبدك بيدك
يعتبر الكبد الدهني حالة صحية شائعة تتطلب اهتمامًا وتشخيصًا دقيقًا. فهم كيفية تحليل دهون الكبد من خلال فحوصات الدم، الخزعة، والتصوير أمر بالغ الأهمية للحفاظ على صحة هذا العضو الحيوي. التشخيص المبكر يمهد الطريق لإدارة فعالة للمرض ويساعدك على تبني نمط حياة صحي يحمي كبدك من التلف. لا تتردد في استشارة المختصين عند الحاجة، فصحة كبدك جزء لا يتجزأ من صحتك العامة.